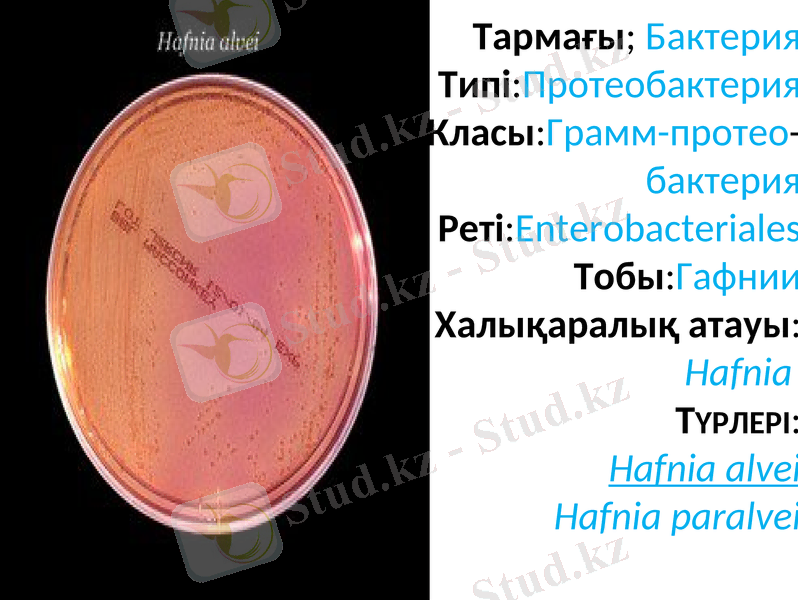
Slide 4

Бал араларының гафниозы (Hafnia alvei): клиникасы, диагностикасы және емдеу мен күресу шаралары



Гафниозды балау және індетке қарсы шаралар

Бал арасының гафниозы (гафниоз пчел) - немесе қылау (паратиф) - іші өтіп, қыстың соңы мен көктемде жаппай қырылуға соқтыратын жұқпалы ауру.

Қоздырушысы - Hafnia alvei (В. paratyphi alvei) үсақ, ұштары жүмыр келген полиморфты таяқшалар, мөлшері 1-2 х 0, 3-0, 5 мкм, спора түзбейді, қозгапмапы (перитрах), барлық анелин бояуларымен жақсы боялады, грам теріс. Микроб жартылай ауасыбағасыз, барлық қарапайым қоректік орталарда, сәл сілтілеу жағдайда жақсы өседі.
Тармағы; Бактерия Типі:Протеобактерия Класы:Грамм-протео- бактерия Реті:Enterobacteriales Тобы:Гафнии Халықаралық атауы: Hafnia Түрлері: Hafnia alvei Hafnia paralvei

Агарда бір тэулік ішінде көгілдір тұнық шоғыр түзеді, түзақпен оңай алынады. Келесі тэулікте шоғырлар бір-бірімен қосылып, бүлыңғыр, жабысқақ тартады. Шоғырдың ортасықоңырланып, бет жағы білеуленіп, дөңестенеді. Сорпада өскенде орта лайланады, индол түзіледі. Сорпаның бетінде кейде бозғылт қабыршақ пайда болады. желатинді сұйылтпайды, сүт ұйымайды. Картофельдё бозғылт сары жүғынды түзіп, бозданған жағымсыз иіс береді.

Глюкозаны, мапьтозаны, арабинозаны, ксилозаны, раманозаны, маннитті, фруктозаны, гапактозаны жэне глицеринді ыдыратады. Лактозаны, сахарозаны, дульцитті, адонитті, раффинозаны, декстринді ыдыратпайды.

Hafnia alvei бактерияларын сапьмонелларлардан мынадай қасиеттері бойынша ажыратады: 20°С-та қозғалмалы, аммоний цитратын ыдыратып, газ түзеді, ал 37°С-та бүл қасиеттері байқапмайды. Сонымен қатар, бүл микробтар өздеріне тэн қан сарысуысмен агглюинация береді. Гафния бактериялары суда қайнатқанда 1-2 минутта, 58-60°С-та 30 минутта өледі.

Індеттік ерекшеліктері. Ауру негізінен қыстың аяғында және көктемде, ап жазда күн суытып, жауынды болғанда байқалады. Оның шығуына араның қоректік балының сапасыз сүйық болуы, орналасқан жерінің суық жэне ылғалдылығы ықпал ететді. Көбінесе жұмысшы аралар ауырады. Қолдан жұқтырғанда қоздырушы бактерияны 5-10% қант шырынына қосып берсе аралардың өлімге ұшырауы күрт көбейеді, ал микробты құрғақ ұнтақ қантпен бергенде аралардың тіршілігі әдеттегіден өзгере қоймайды.

Көктемде ара ұяларын қысқы орынынан шығарғанда, кәрездерді ауыстырғанда, адасқан аралар арқылы, ортақ ыдыстан суарғанда ауру сау ұяның араларына жұғады. Өлім көрсеткіші, ара орыны ылғалды болғанда, 50-60%-ға жетеді.


Өтуі мен симптомдары. Жасырын кезеңі 3-14 күн. Гафниоздың өзгеше клиникалық белгілері болмайды. Ауырған ара ұша алмай жорғалап жүреді. Құрсак бөлігі қампиып, іші өтеді. Тыныс ала алмай, кейде аяқтары салданады. Ауру жіті өткенде араның шығыны мол болады. Көктемде ұша бастағанда аралар иісі жағымсыз, жабысқақ, сұйылған, шамадан тыс көп мөлшерде бозғылт-қоңыр түсті нәжіс бөліп шығарады.

Көктемгі ұшуы сылбыр болады. Омартаны тексергенде қорек қоры мол, бірақ барлық кәрездер қоңырқай жабысқақ немесе сұйық экскременттермен былғанған. Ауырған араны сойып көргенде ішектері кеуіп, ластанған ақшыл немесе ақшыл сұрғылт түсті болады.

Гафниоздан өлген аралар

Балау клиникалық жэне індеттанулық деректерге сүйене отырып, мін- детті түрде ауру қоздырушы микробты бөліп алып, оны бактериологиялық жэне серологиялық айқындауға негізделеді. Таза өсін алу үшін әдетте өлген араның ішегі мен гемолимфасынан немесе кеуде етінен Эндо ортасында егеді.

Дауалау және күресу шаралары. Аралардың күтімін жақсарту әдетте ауруды тоқтатады. Аралардың шығыны көп болған жағдайда оларға 3 рет арасына 1 апта аралатып 1 л 50% қант шырынына қосып төмендегі антибиотиктердің бірін: левомецитин 0, 2г, стрептомицитин 200 мың ӘБ, биомицин 100 мың ӘБ береді.

Емдік мақсатқа дайындалғанқант шырыны

Назарларынызға рахмет!!!
- Іс жүргізу
- Автоматтандыру, Техника
- Алғашқы әскери дайындық
- Астрономия
- Ауыл шаруашылығы
- Банк ісі
- Бизнесті бағалау
- Биология
- Бухгалтерлік іс
- Валеология
- Ветеринария
- География
- Геология, Геофизика, Геодезия
- Дін
- Ет, сүт, шарап өнімдері
- Жалпы тарих
- Жер кадастрі, Жылжымайтын мүлік
- Журналистика
- Информатика
- Кеден ісі
- Маркетинг
- Математика, Геометрия
- Медицина
- Мемлекеттік басқару
- Менеджмент
- Мұнай, Газ
- Мұрағат ісі
- Мәдениеттану
- ОБЖ (Основы безопасности жизнедеятельности)
- Педагогика
- Полиграфия
- Психология
- Салық
- Саясаттану
- Сақтандыру
- Сертификаттау, стандарттау
- Социология, Демография
- Спорт
- Статистика
- Тілтану, Филология
- Тарихи тұлғалар
- Тау-кен ісі
- Транспорт
- Туризм
- Физика
- Философия
- Халықаралық қатынастар
- Химия
- Экология, Қоршаған ортаны қорғау
- Экономика
- Экономикалық география
- Электротехника
- Қазақстан тарихы
- Қаржы
- Құрылыс
- Құқық, Криминалистика
- Әдебиет
- Өнер, музыка
- Өнеркәсіп, Өндіріс
Қазақ тілінде жазылған рефераттар, курстық жұмыстар, дипломдық жұмыстар бойынша біздің қор #1 болып табылады.



Ақпарат
Қосымша
Email: info@stud.kz